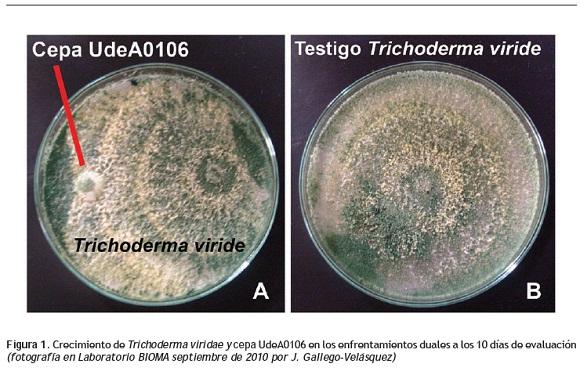

Services on Demand
Journal
Article
Indicators
-
 Cited by SciELO
Cited by SciELO -
 Access statistics
Access statistics
Related links
-
 Cited by Google
Cited by Google -
 Similars in
SciELO
Similars in
SciELO -
 Similars in Google
Similars in Google
Share
Actualidades Biológicas
Print version ISSN 0304-3584
Actu Biol vol.36 no.101 Medellín July/Dec. 2014
ARTÍCULOS DE INVESTIGACIÓN
Compatibilidad del hongo entomopatógeno Purpureocillium sp. cepa UdeA0106 con biocontroladores y productos fitosanitarios utilizados en cultivos de crisantemo
Compatibility of the entomopathogenic fungus Purpureocillium sp. cepa UdeA0106 with biocontrollers fungi and plant protection products, used on chrysanthemum crops
Jenny Gallego-Velásquez1, Nadya L. Cardona-Bustos2, Fernando Restrepo-Betancur3
1 Grupo Bioma (Biocontrol y Microbiología Ambiental). Instituto de Biología, Universidad de Antioquia. Medellín (Antioquia), Colombia. jey428@yahoo.com.ar
2 Docente, Grupo de Investigación Bioma (Biocontrol y Microbiología Ambiental). Instituto de Biología, Universidad de Antioquia. Medellín (Antioquia), Colombia. nadya.cardona@udea.edu.co
3 Docente, Grupo de Investigación Grica, Facultad de Ciencias Agrarias, Universidad de Antioquia. Medellín (Antioquia), Colombia. fercho7474@hotmail.com
Recibido: abril 2013; aceptado: marzo 2014.
Resumen
El hongo entomopatógeno Purpureocillium sp. cepa UdeA0106 ha mostrado potencial para el control de sinfílidos (Scutigerella sp.), una plaga que ataca los cultivos de crisantemo, tanto in vitro como bajo condiciones de invernadero. En la actualidad, la cepa Purpureocillium sp. UdeA0106 se aplica en combinación con otros hongos biocontroladores, fungicidas e insecticidas en los sistemas de manejo integrado (IPM) en cultivos de crisantemo en el oriente de Antioquia, Colombia. Sin embargo, los aspectos ecológicos relacionados con la compatibilidad del hongo UdeA0106 y estas estrategias de control son desconocidos. Uno de los objetivos del presente trabajo fue la evaluación del antagonismo in vitro de la cepa Purpureocillium sp. UdeA0106 con los biocontroladores Beauveria bassiana (Vuill., 1912), Metarhizium anisopliae (Sorokin, 1883), Paecilomyces lilacinus [(Thom) Luangsa-ard, Houbraken, Hywel-Jones & Samson, 2011] y Trichoderma viride (Pers., 1794). Adicionalmente, y bajo condiciones de laboratorio, se estudió el efecto de productos fitosanitarios aplicados de forma regular en los cultivos de flores sobre Purpureocillium sp. UdeA0106. Los resultados obtenidos mostraron que el hongo UdeA0106 presentó compatibilidad in vitro con la mayoría de los hongos biocontroladores excepto con T. viride, mientras que el fungicida Carbovax® (carboxina + tiram) inhibió completamente la germinación y el crecimiento vegetativo del hongo. Los avances en la comprensión de la compatibilidad del hongo con otros productos que se aplican comúnmente en los cultivos de flores, permitirán un uso más eficiente de Purpureocillium sp. cepa UdeA0106 para el control de sinfílidos en cultivos de crisantemo.
Palabras clave: antagonismo, Purpureocillium sp. cepa UdeA0106, control biológico, hongos entomopatógenos, protección de cultivos.
Abstract
The entomopathogenic fungus Purpureocillium sp. strain UdeA0106 was isolated in soil from a farm belonging to the Universidad de Antioquia. This fungus has shown potential in vitro and under greenhouse conditions to control symphylans (Scutigerella sp.) , a pest that attacks chrysanthemum crops, whose control has been achieved with the use of some insecticides, which temporarily reduce populations but without the desired efficiency throughout the cultivation cycle. Currently the Purpureocillium sp. strain UdeA0106 is applied in combination with another biocontrol fungi, fungicides and insecticides in the integrated pest management systems (IPM) for chrysanthemum crops (eastern Antioquia); however, the ecological aspects related to the compatibility of the fungus Purpureocillium sp. strain UdeA0106 and the control strategies are unknown. The goals of the present study were to evaluate the in vitro antagonism of Purpureocillium sp. strain UdeA0106, with the biocontroller Paecilomyces lilacinus (Samson 1974), Beauveria bassiana (Vuill. 1912), Metarhizium anisopliae (Sorokīn 1883) and Trichoderma viride (Pers. 1794), using the dual plates method, and to study the effect of plant protection products applied regularly in flower crops on Purpureocillium sp. strain UdeA0106, under laboratory conditions. The results obtained demonstrated that the fungus Purpureocillium sp. strain UdeA0106 showed in vitro compatibility with the majority of the biocontrol fungi, except with Trichoderma viride. The fungicide Carbovax® (carboxin + thiram) completely inhibited germination and vegetative growth of the fungus. The advances in the understanding of the compatibility of this fungus with other products commonly applied on flower crops will enable in the future a more efficiently use of the fungus Purpureocillium strain UdeA0106, to control this pest in chrysanthemum crops.
Key words: Antagonism, Purpureocillium sp., UdeA0106, biological control, entomopathogenic fungi, crop protection.
INTRODUCCIÓN
El sistema de manejo integrado (IPM = Integrated pest management) busca reducir significativamente la dependencia de los plaguicidas químicos, para esto se apoya en la utilización de métodos de control biológico (Reino et al. 2008) entre los que se encuentran los hongos, organismos potencialmente considerables en el manejo y reducción de insectos, enfermedades y malezas (Charudattan 2001, Loureiro y Moino 2006, Spadaro y Gullino 2005). En la actualidad se han incrementado de manera significativa las investigaciones sobre nuevas estrategias de control, hecho que se refleja en un aumento en el número de agentes de biocontrol disponibles en el mercado o en fase de estudio (Bailey et al. 2010, Roselló 2003).
La utilización de hongos en el control de plagas y enfermedades ofrece una serie de beneficios que promueven su uso. Específicamente, los hongos entomopatógenos demuestran un considerable potencial en el control de insectos plaga, permiten el desarrollo de cultivos más sostenibles, reducen el impacto ambiental y son más efectivos por tener blancos de acción más específicos que los productos químicos (Spadaro y Gullino 2005, Butt y Copping 2000). Este grupo de biocontroladores incluye cerca de 90 géneros y 700 especies de los cuales, los más utilizados están ubicados principalmente en el grupo de los hongos anamórficos o fases asexuales de Ascomycota y Zigomycota (Entomophtorales) (Luz et al. 2007, Vega et al. 2009).
En general, y a pesar de sus beneficios, la eficiencia en la actividad de hongos entomopatógenos para el control de insectos-plaga, puede verse afectada al momento de su aplicación en campo debido a factores abióticos como la humedad, la temperatura y el uso conjunto con agroquímicos, así como por los problemas que se presentan en la interacción con otros microorganismos biocontroladores que pueden convertirse en antagonistas (Cuthbertson et al. 2005, Yáñez y France 2010). Las diferentes interacciones entre estos factores permiten que el desarrollo de cada entomopatógeno difiera de otro y dependa siempre de cada condición y de las características particulares del organismo.
Los factores bióticos y abióticos mencionados anteriormente, no permiten que los hongos biocontroladores logren reemplazar totalmente el uso de insecticidas, fungicidas y herbicidas, lo que ha llevado a que se usen en conjunto para generar, en algunos casos, mayores beneficios en el control de problemas fitosanitarios (Ambethgar 2009, Cuthbertson et al. 2010, Morales y Peck 2009, Purwar y Sachan 2005, Roberti et al. 2006). Lo anterior hace posible que el control de patógenos sea más eficiente por sinergismo o efectos aditivos, adicionalmente, el uso de productos químicos y hongos biocontroladores disminuye el impacto ambiental generado por los compuestos sintéticos, puesto que se reduce en gran medida la cantidad que se aplica de estas sustancias (Alizadeh et al. 2007, Mochi et al. 2005, Spadaro y Gullino 2005). Sin embargo, varios estudios documentan el efecto que muchos agroquímicos tienen sobre la germinación y crecimiento vegetativo de hongos entomopatógenos (Alizadeh et al. 2007, Cuthbertson et al. 2008, Durán 1998, Luz et al. 2007, Muhammad et al. 2010, Neves et al. 2001, Olán y Cortez 2003, Ramaraje et al. 1967, Vásquez et al. 2004, Yáñez y France 2010). Las conclusiones de estas investigaciones son diversas y aunque la tendencia indica que los fungicidas son el grupo más perjudicial para entomopatógenos, los resultados varían considerablemente con respecto a la especie del hongo y su combinación con diferentes tipos de agroquímicos, y a la concentración de los ingredientes activos (Castiglioni et al. 2003). Es por esto que, con cada hongo controlador y con cada agroquímico probado, pueden obtenerse resultados de compatibilidad o incompatibilidad específicos para cada caso en particular (Klingen y Haukeland 2006).
Los estudios de compatibilidad de hongos con productos fitosanitarios (agroquímicos) se han realizado en gran medida en ensayos de laboratorio, donde es posible determinar la velocidad de crecimiento, la esporulación y la germinación del microorganismo en presencia de un químico (Loureiro et al. 2002). Estos estudios in vitro exponen al máximo el microorganismo a la acción del producto sintético y brindan confiabilidad sobre los resultados de compatibilidad (Alves et al. 1998, citado por Castiglioni et al. 2003). Asimismo, hacen posible un primer análisis antes de probarlos en campo; se convierten en importantes estudios de impacto económico-ambiental, y permiten seleccionar los agrotóxicos que podrían utilizarse en combinación con agentes biocontroladores (Mourão et al. 2003). Por otro lado, el uso combinado de diferentes agentes de control biológico para combatir múltiples patógenos dentro de un mismo cultivo, es una práctica común en la actualidad, ya que al aplicarse individualmente pueden no ser lo suficientemente efectivos y el rango de patógenos del suelo no es totalmente controlado (Roberts et al. 2005). Es así como diferentes cepas de hongos como Beauveria sp., Lecanicillim sp., Metarhizium sp., Paecilomyces sp., Trichoderma sp., entre otros, son aplicados tradicionalmente en combinación para atacar diferentes organismos blanco, dado que pueden presentar distintos mecanismos de acción (Anastasiadis et al. 2008, Ezziyyani et al. 2004, Ganassi et al. 2010, Quesada et al. 2006, Whipps 2001).
Las ventajas de los agentes de control biológico aplicados en combinación incluyen: múltiples modos de acción contra los diferentes patógenos; capacidad de afectar más de una etapa del ciclo de vida del organismo blanco; actividad específica de los microorganismos en diferentes épocas del cultivo; un espectro más amplio de acción en los que no se vean afectados por las condiciones del suelo, derivadas de los diferentes ambientes a los que se adaptan los microorganismos aplicados; y por último, el potencial para seleccionar los organismos que afectan a más de un patógeno o plaga, aumentando así el espectro de acción de los productos (Meyer y Roberts 2002). En general, las mezclas de biocontroladores funcionan de manera exitosa si ellos exhiben modos de acción diferentes o complementarios y si la habilidad para colonizar ''micro sitios'' en la rizosfera es alto, como ocurre naturalmente (Whipps 2001).
No obstante, al combinar diferentes microorganismos biocontroladores, los resultados pueden no ser favorables, dado que, el mecanismo de acción de unos puede inhibir parcial o totalmente el buen desempeño de otros (Anees et al. 2010). Una hipótesis propuesta por Meyer y Roberts (2002) menciona que los efectos negativos o ineficiencia en la combinación de biocontroladores están dados, precisamente, porque uno de los agentes integrantes de la mezcla presenta un mecanismo de represión tan alto que puede suprimir la acción de otro biocontrolador, de la misma manera en la que antagoniza o suprime un patógeno.
Dependiendo de cada caso y de los microorganismos involucrados, puede tornarse difícil determinar cuál de los microorganismos utilizados en conjunto es el que realmente ejerce una acción eficaz. En muchos casos, el uso de varios agentes puede reducir la probabilidad de éxito en el proceso de competencia y causar la exclusión (Denoth et al. 2002), lo que generaría impacto negativo en el programa de control biológico implementado (Woo y Loritto 2007), e incluso, podría tener efectos directos o indirectos sobre especies no blanco (Pearson y Callaway 2005). Por tal motivo, la compatibilidad entre organismos biocontroladores debe ser estudiada previamente al empleo de estos como parte de un programa de manejo integrado, con el fin de obtener los resultados deseados.
Estudios preliminares, tanto de laboratorio como en campo, realizados con Purpureocillium sp. cepa UdeA0106 –un hongo entomopatógeno encontrado en suelos de una finca propiedad de la Universidad de Antioquia–, el cual ha mostrado resultados promisorios que indican la capacidad de este hongo para micosar sinfílidos (Scutigerella sp.), una plaga que produce pérdidas entre el 25 y el 50% de la producción en cultivos de flor (Navarro y Gaviria 2001, Zuluaga et al. 2007) y que no ha podido ser controlada con manejo químico tradicional (com. pers. Flores Esmeralda C.I). Considerando la importancia que puede tener la inclusión del hongo entomopatógeno Purpureocillium sp. cepa UdeA0106 en programas de manejo integrado para control de sinfílidos, se propuso un trabajo de investigación cuyo objetivo principal fue determinar la compatibilidad de este hongo con otros microorganismos biocontroladores y con productos químicos de frecuente aplicación, utilizados en cultivos de crisantemo. Los resultados de esta investigación permitieron ampliar el conocimiento sobre Purpureocillium sp. cepa UdeA0106 y suministraron información necesaria para la utilización exitosa de este microorganismo en futuros programas de manejo integrado de plagas del crisantemo.
MATERIALES Y MÉTODOS
Compatibilidad de Purpureocillium sp. cepa UdeA0106 con biocontroladores utilizados en cultivos de crisantemo. Microorganismos. La cepa del hongo entomopatógeno Purpureocillium sp. cepa UdeA0106 fue proporcionada por el Laboratorio BIOMA (Biocontrol y Microbiología Ambiental) de la Universidad de Antioquia. Este hongo hace parte del cepario del Laboratorio desde el año 2006, cuando fue aislado de suelos de una finca propiedad de la Universidad de Antioquia en el municipio de Gómez Plata (Antioquia), Colombia. Los hongos biocontroladores utilizados en las pruebas de compatibilidad como: Beauveria sp. (BFE08), Metarhizium sp. (MFE08), Paecilomyces sp. (PFE08) y Trichoderma sp. (TFE08), fueron suministrados por el floricultivo Flores Esmeralda S. A. en el Oriente antioqueño. Estos hongos fueron producidos en masa en sustratos orgánicos como el arroz y son utilizados en el control de plagas y enfermedades del cultivo.
Almacenamiento de los hongos biocontroladores. El almacenamiento de los hongos biocontroladores, incluido Purpureocillium sp. cepa UdeA0106, se hizo en el medio Sabouraud-SDA (4% dextrosa agar de Merck: peptona de caseína 5 g/l, peptona de carne 5 g/l, D(+)-glucosa 40 g/l, agar-agar 15 g/l); acidificado con ácido láctico al 40% (pH 4,6 ± 2), el cual fue preparado según las especificaciones del fabricante. Una vez sembradas las cepas en el medio de cultivo, se incubaron (incubadora BTC binder) por 10 días a 25 °C, con el fin de obtener buen crecimiento de los hongos para los ensayos de enfrentamiento dual. Se realizó una identificación microscópica de los hongos. Para la muestra de Purpureocillium sp. cepa UdeA0106, se siguió la descripción taxonómica propuesta por Luangsa et al. 2011. Para las demás muestras de hongos biocontroladores, se siguieron las claves taxonómicas de Barnett y Carmichael (Morales 2009). Las cepas de los hongos biocontroladores utilizadas en este estudio fueron almacenadas en condiciones de refrigeración como parte del cepario del Grupo BIOMA.
Identificación molecular de los hongos biocontroladores. Con el fin de comprobar el género y la especie, la caracterización molecular de los hongos biocontroladores TFE08, PFE08, BFE08, MFE08 se llevó a cabo por PCR convencional del ADNr, mediante los primers PN3-PN16, el producto de amplificación fue secuenciado en Macrogen (Corea). La secuencia obtenida fue analizada con la herramienta Basic Local Alignment Search Tool (BLAST) (BLAST 2013) de la base de datos del GenBank.
Enfrentamiento dual de Purpureocillium sp. cepa UdeA0106 con hongos biocontroladores. La compatibilidad de P. lilacinum cepa UdeA0106 con otros hongos biocontroladores se realizó mediante enfrentamiento dual en caja de Petri con el medio de cultivo SDA acidificado. Para esto, se sembró en un extremo de la caja de Petri un disco de 5 mm de diámetro de micelio de un hongo biocontrolador (10 días de crecimiento); en el extremo opuesto y a 5 cm de distancia, se sembró Purpureocillium sp. cepa UdeA0106 (Suárez et al. 2008). Además, se incluyó de cada hongo un testigo en el cual se sembró un disco de agar con micelio en el centro de una caja de Petri (hongo sin enfrentar). Los medios de cultivo inoculados se incubaron por espacio de 10 días a 25 ± 2 °C. Para cada tratamiento se usaron 5 repeticiones.
La evaluación del antagonismo se realizó los días 5 y 10, y se midió el crecimiento radial de la colonia de cada hongo enfrentado y de los testigos. El crecimiento radial de cada colonia se determinó mediante medición del diámetro en mm, haciendo dos lecturas, una en sentido vertical y otra horizontalmente, luego se calculó el promedio de estas dos lecturas; al dato obtenido (diámetro promedio) se le restó el valor del disco de inóculo (5 mm) y el nuevo valor fue dividido entre 2 para obtener el radio de la colonia. El antagonismo in vitro se estableció por comparación entre los radios de crecimiento (mm) de las cepas enfrentadas y sus testigos (Suárez et al. 2008). También se estableció el porcentaje de inhibición de crecimiento radial (PICR) mediante la aplicación de la fórmula descrita por Ezziyyani et al. (2004):

Donde:
R1: radio del hongo testigo
R2: radio del hongo en cultivo dual o enfrentado
Compatibilidad de Purpureocillium sp. cepa UdeA0106 con productos fitosanitarios utilizados comúnmente en cultivos de crisantemo. Las pruebas de compatibilidad con productos fitosanitarios se hicieron a partir de cultivos del hongo Purpureocillium sp. cepa UdeA0106 con 10 días de crecimiento en medio papa dextrosa agar (PDA) de Merck (infusión de papa 4 g/l, glucosa 20 g/l, agar-agar 15 g/l), preparado según las especificaciones del fabricante.
Selección de productos fitosanitarios y preparación del medio de cultivo. Los productos fitosanitarios (agroquímicos) utilizados en las pruebas de compatibilidad con el hongo Purpureocillium sp. cepa UdeA0106, fueron seleccionados teniendo en cuenta aquellos utilizados comúnmente para el control de enfermedades y plagas en suelo de cultivos de crisantemo. Se diluyeron cada uno de los productos fitosanitarios hasta alcanzar la dosis recomendada por el fabricante, en medio PDA a 40 ºC (Corredor et al. 2007); luego se vertieron en cajas de Petri y se dejaron solidificar. En cada uno de estos medios preparados, se evaluó el crecimiento radial de Purpureocillium sp. cepa UdeA0106 en presencia de agroquímicos.
Evaluación de la germinación de conidios. La evaluación de la germinación de los conidios se hizo a partir de suspensiones acuosas de conidios del hongo, ajustadas a concentración de 107 conidios/ml en un volumen final de 10 ml de agua destilada estéril. Los tratamientos correspondieron a cada agroquímico disuelto por separado en la suspensión acuosa de esporas y, como control, se utilizó una suspensión acuosa sin agroquímico. La dosis utilizada para cada agroquímico es indicada en la tabla 1. Las preparaciones de conidios-agroquímico se dejaron en reposo por espacio de una hora y luego se añadieron de forma individual a cajas Petri con agar bacteriológico, las cuales fueron marcadas exteriormente con una cuadrícula de 2 x 2 cm para indicar el sitio en donde debía ser depositado el inóculo fúngico. En cada cuadrícula de cada caja se depositaron por separado alícuotas de 5 μl en el medio de cultivo y se incubaron 20 horas a 20 ± 5 ºC. Se utilizaron siete tratamientos suspensión de conidiosagroquímico con tres repeticiones e igual número de testigos (tabla 1). Para evaluar el porcentaje de germinación se cortaron fragmentos de agar de 2 cm aproximadamente, que contenían la siembra de conidios-agroquímico y se depositaron en un portaobjetos. A cada sección se le adicionó una gota de colorante azul de lactofenol y se les puso un cubre objeto. Mediante observación al microscopio óptico (40X) de las muestras tratadas con los agroquímicos, se eligió un campo óptimo de lectura donde se contaron 100 conidios, determinando el número de conidios germinados y no germinados. El dato del porcentaje de germinación se comparó con el de la respectiva muestra testigo [metodología adaptada de Neves et al. (2001)].
Evaluación del crecimiento vegetativo de Purpureocillium sp. cepa UdeA0106. Para el análisis del crecimiento vegetativo de P. lilacinum cepa UdeA0106 en presencia de agroquímicos, se sembró un disco de 5 mm de diámetro de micelio joven del hongo en el centro de la caja de Petri, que contenía medio de cultivo preparado como fue descrito anteriormente. Estas preparaciones se incubaron por 10 días a 20 ± 5 °C protegidos de la luz directa. Los días 5 y 10 del experimento se midió el radio de crecimiento (mm) de las colonias, para lo cual se siguió el mismo procedimiento utilizado en las pruebas de compatibilidad con biocontroladores (véase, Enfrentamiento dual de Purpureocillium sp. cepa UdeA0106 con hongos biocontroladores).
El radio de la colonia de Purpureocillium sp. cepa UdeA0106 en los diferentes tratamientos, fue comparado con el radio de crecimiento del testigo, hongo crecido en medio PDA sin producto químico e incubado en las mismas condiciones de los tratamientos. Adicionalmente, se determinó el porcentaje de inhibición de las colonias utilizando la fórmula proporcionada por Mourão et al. (2003):

Análisis estadístico. Se empleó un diseño de clasificación experimental completamente aleatorizado de efecto fijo balanceado. El número de repeticiones por tratamiento en todas las pruebas fue de cinco y la unidad experimental fue la caja de Petri. Todos los análisis se llevaron a cabo utilizando ANOVAS y la prueba estadística de Tukey, con nivel de confianza del 95% (p = 0,05). En las pruebas de compatibilidad de P. lilacinum cepa UdeA0106 con otros biocontroladores, las variables evaluadas fueron los radios de crecimiento de los hongos. En los ensayos de compatibilidad con productos fitosanitarios, las variables evaluadas fueron el radio de crecimiento de P. lilacinum cepa UdeA0106 y el porcentaje de germinación. Para todos los análisis se utilizó el paquete estadístico SAS® 9.1 (Instituto SAS, Carolina del Norte, E. U. A.) con el procedimiento Modelo Lineal General (GLM).
RESULTADOS
El género y especie de los biocontroladores utilizados fue comprobado por secuenciación de su región de ADNr con los cebadores PN3 y PN16, y sometidos a BLAST en el GenBank. De esta manera, pudo establecerse que los hongos correspondieron a Beauveria bassiana (Vuill., 1912), Metarhizium anisopliae (Sorokin, 1883), Paecilomyces lilacinus [(Thom) Luangsa-ard, Houbraken, Hywel-Jones & Samson, 2011] y Trichoderma viride (Pers., 1794).
Compatibilidad de Purpureocillium sp. cepa UdeA0106 con biocontroladores utilizados en cultivos de crisantemo. Efecto de hongos biocontroladores sobre el crecimiento de Purpureocillium sp. cepa UdeA0106. En las evaluaciones realizadas para el día 5 de los ensayos, se observó que los biocontroladores B. bassiana, M. anisopliae, P. lilacinus y T. viride no tuvieron efectos sobre el crecimiento radial de Purpureocillium sp. cepa UdeA0106. Al comparar el radio (mm) de crecimiento de P. lilacinum cepa UdeA0106 con el radio de crecimiento de su respectivo testigo, no se encontraron diferencias significativas (p > 0,05). Sin embargo, cabe destacar que el crecimiento radial en mm de P. lilacinum cepa UdeA0106, para este día, fue mayor cuando estuvo enfrentada con P. lilacinus (tabla 2). Al establecer el porcentaje de inhibición de Purpureocillium sp. cepa UdeA0106 para el día 5, cuando está enfrentada con B. bassiana, M. anisopliae y P. lilacinus se obtuvieron valores negativos. Al enfrentar a Purpureocillium sp. cepa UdeA0106 con T. viride el porcentaje de inhibición fue positivo (5%) (tabla 2).
Cuando se evaluó el enfrentamiento de Purpureocillium sp. cepa UdeA0106 con T. viride en el día 10 del experimento, se encontraron diferencias significativas (p < 0,05) en el crecimiento de P. lilacinum cepa UdeA0106. En este tratamiento, el crecimiento de hongo disminuyó en comparación con su respectivo testigo. Adicionalmente, se observó que el antagonista continuó su crecimiento miceliar por encima de P. lilacinum cepa UdeA0106 (figura 1 A).
Para este mismo día de evaluación (día 10), no se encontraron efectos de disminución en el radio de crecimiento de P. lilacinum cepa UdeA0106 al enfrentarse con los hongos entomopatógenos B. bassiana, M. anisopliae y P. lilacinus (p > 0,05). Al comparar en cada tratamiento el radio de crecimiento de Purpureocillium sp. cepa UdeA0106 con el radio de crecimiento de su respectivo testigo, no se encontraron diferencias significativas (p > 0,05). Los porcentajes de inhibición de Purpureocillium sp. cepa UdeA0106 en combinación con M. anisopliae y P. lilacinus continuaron mostrando datos negativos, tal y como se observó para el día 5, mientras que con B. bassiana no se observó inhibición (tabla 2).
Efecto de Purpureocillium sp. cepa UdeA0106 sobre hongos biocontroladores. En el día 5, el crecimiento de T. viride enfrentado con Purpureocillium sp. cepa UdeA0106, fue significativamente menor que el de su respectivo testigo (p < 0,05). Este fenómeno fue disminuyendo progresivamente hasta el día 10, sin dejar de ser estadísticamente significativo. Durante toda la prueba, los demás biocontroladores (B. bassiana, M. anisopliae y P. lilacinus) no presentaron cambios en su crecimiento en presencia de Purpureocillium sp. cepa UdeA0106. Los datos del efecto de P. lilacinum cepa UdeA0106 sobre los diferentes biocontroladores y las respectivas comparaciones, se encuentran relacionados en la tabla 3.
Compatibilidad de Purpureocillium sp. cepa UdeA0106 con productos fitosanitarios utilizados comúnmente en cultivos de crisantemo. Efecto de productos fitosanitarios (agroquímicos) sobre la germinación de Purpureocillium sp. cepa UdeA0106. La observación de los diferentes tratamientos (UdeA0106-agroquímico) arrojó resultados que permitieron establecer que el fungicida Carbovax® (carboxin + thiram), fue el único tratamiento que no permitió la germinación de Purpureocillium sp. cepa UdeA0106 en el tiempo evaluado y que evidencia efecto significativo (p < 0,05). Por el contrario, en comparación con la germinación observada en el testigo, la combinación del hongo UdeA0106 con los agroquímicos Engeo® (Thiametoxan), Moncut® (Flutolanil), Rhapsody® (Bacillus subtillis), Previcur® (propamocarb), Tachigaren® (Hymexazol) y Terrazole® (Etridiazole), no mostró efectos negativos en el desarrollo de tubos germinativos del hongo. Los porcentajes de germinación del hongo UdeA0106 en estos tratamientos fue mayor a 93% en todos los casos, incluso se observó que el tratamiento con el insecticida Engeo® presentó una germinación poco mayor a la observada para el testigo (tabla 4).
Efecto de productos fitosanitarios (agroquímicos) sobre el crecimiento vegetativo de Purpureocillium sp. cepa UdeA0106. El estudio de la combinación in vitro de productos fitosanitarios con Purpureocillium sp. cepa UdeA0106, reveló que los fungicidas Carbovax® (Carboxin), Tachigaren® (Hymexazol) y Terrazole® (Etridiazole) inhiben por completo el crecimiento vegetativo del hongo, según las observaciones realizadas los días 5 y 10 de la prueba (tabla 5). La exposición del hongo a Rhapsody® (Bacillus subtillis) causó inhibición del crecimiento de 84% al día 5 de la prueba y 87% al final de la misma (día 10). El tratamiento con el fungicida Moncut® (Flutolanil) afectó el desarrollo del hongo en 27% al día 5 y 34% al día 10, comparados con el crecimiento de su respectivo testigo. En contraste, la presencia del fungicida Previcur® (propamocarb) no mostró evidencia estadística (p > 0,05) de causar algún efecto en el hongo, su crecimiento en este tratamiento fue similar al observado en el testigo (tabla 5). Al evaluar el efecto del insecticida Engeo® (Thiametoxan) sobre Purpureocillium sp. cepa UdeA0106, se observó que en los primeros 5 días del tratamiento tuvo efecto retardado sobre el crecimiento radial del hongo (p < 0,05). Este resultado al final de la prueba (día 10) fue completamente distinto a lo observado inicialmente, el crecimiento vegetativo del hongo no fue estadísticamente diferente al de su testigo (p > 0,05) (tabla 5).
DISCUSIÓN
El uso de diferentes hongos como agentes de control biológico dentro de un programa de manejo integrado, busca que los beneficios de cada organismo en particular no interfieran con otros factores. En el presente estudio, se analizó la compatibilidad de P. lilacinum cepa UdeA0106 con otros hongos biocontroladores como B. bassiana, M. anisopliae, P. lilacinus y T. viride así como con algunos productos de síntesis química. Con respecto a los hongos biocontroladores evaluados, los ensayos realizados durante 10 días permitieron establecer in vitro, si el crecimiento radial de alguno de ellos fue afectado por la combinación de Purpureocillium sp. cepa UdeA0106 o si este afectó a alguno de los entomopatógenos evaluados. Los datos obtenidos del porcentaje de inhibición de UdeA0106, cuando es enfrentado con los de B. bassiana, M. anisopliae y P. lilacinus podrían significar que la coexistencia con otros hongos entomopatógenos beneficia o estimula el crecimiento de Purpureocillium sp. cepa UdeA0106 debido, posiblemente, a un efecto sinérgico.
A pesar de haberse resaltado leve aumento en el crecimiento radial de Purpureocillium sp. cepa UdeA0106, no puede desconocerse que el crecimiento de los demás hongos (B. bassiana, M. anisopliae y P. lilacinus) no se vio afectado durante todo el proceso de experimentación, lo que sugiere que a nivel in vitro estos microorganismos fueron compatibles.
Con relación al leve incremento presentado en algunos casos por P. lilacinum cepa UdeA0106, es factible decir que probablemente esta utilizó alguna sustancia o metabolito secundario producido in vitro por los otros hongos, lo cual favorecería su desarrollo. Por otra parte, este hongo podría tener la capacidad de asimilar con mayor rapidez componentes del medio, lo que beneficiaría su crecimiento. Es importante mencionar que, hasta el momento del desarrollo de la presente investigación, no se encontraron registros con respecto a las ventajas competitivas relacionadas con la asimilación de compuestos durante las interacciones de los géneros trabajados, por lo que este tema podría convertirse en objeto de mayor estudio en un futuro.
Por otra parte, y a diferencia de lo anterior, en esta investigación se observó que pueden existir hongos que alteran el crecimiento de la cepa en estudio. Un ejemplo de ello, es que en el enfrentamiento dual de Purpureocillium sp. cepa UdeA0106 con T. viride este tuvo la capacidad de inhibirlo, aun cuando en las primeras lecturas el resultado no fue estadísticamente significativo (p > 0,05) y no se consideró interferencia negativa. Sin embargo, los resultados al final de la experimentación (día 10) mostraron inhibición de Purpureocillium sp. cepa UdeA0106 del 58,7%, en donde la colonia de Purpureocillium sp. cepa UdeA0106 se vio notablemente reducida de tamaño y gran parte de la caja de Petri estaba ocupada por micelio de T. viride. Este resultado puede encontrar explicación en estudios que demuestran que Trichoderma sp. interfiere con el desarrollo de otros hongos mediante diferentes mecanismos, entre los que se hallan principalmente, la competencia por nutrientes y espacio (Thrane et al. 2000), y la velocidad de crecimiento, pues está adaptado biológicamente para colonizar con agresividad distintos sustratos (Dubey et al. 2007, Infante et al. 2009, Suárez et al. 2008). La inhibición presentada en el crecimiento de Purpureocillium sp. cepa UdeA0106 en el tratamiento con T. viride, reitera que el género Trichoderma sp. interfiere con el desarrollo de un amplio rango de hongos. Un ejemplo de ello fue registrado por Moino y Batista (1999), quienes describieron efectos negativos en el crecimiento y desarrollo de B. bassiana y M. anisopliae, cuando fueron inoculados al mismo tiempo con Trichoderma sp. Con el fin de mitigar el efecto negativo ocasionado por este hongo sobre el crecimiento de otros entomopatógenos, estos autores estudiaron la posibilidad de realizar inoculaciones iniciales de los entomopatógenos, previa la aplicación de Trichoderma sp., con el objetivo de lograr el establecimiento previo en el suelo. Lo anterior, con el fin de aumentar las poblaciones de entomopatógenos que les permitan competir por nutrientes y espacio, protegiéndolos de una acción inmediata del antagonista. Debido a esto, se esperaría que al alternar o cambiar los tiempos de aplicación de los biocontroladores, los efectos antagónicos puedan ser reducidos.
De acuerdo con la presente investigación, y con el fin de determinar el efecto real de Trichoderma sp. sobre la cepa en estudio, es necesario evaluar en campo el efecto de los diferentes tiempos de aplicación de este, en el establecimiento de Purpureocillium sp. cepa UdeA0106 en suelo. Por otra parte, al realizarse el estudio de la posible interferencia de la cepa UdeA0106 en el crecimiento de otros biocontroladores, se observó que esta no tuvo efectos inhibitorios sobre el crecimiento de P. lilacinus, B. bassiana y M. anisopliae. Sin embargo, mostró inhibición sobre T. viride, efecto que tuvo mayor incidencia al inicio de la prueba (30% de inhibición para el día 5) y fue disminuyendo en la medida en que avanzó el estudio (6,6% para el día 10), aunque siempre fue estadísticamente significativo (p < 0,05) durante el tiempo de la evaluación in vitro. Posiblemente, en los primeros días, la competencia por los nutrientes y el espacio disponible pudo haber sido más fuerte en Purpureocillium sp. cepa UdeA0106, por lo que logró disminuir el crecimiento de T. viride. Adicional a esto, no se descarta la posibilidad de que Purpureocillium sp. cepa UdeA0106 haya secretado algún tipo de sustancia inhibitoria que afectara negativamente el desarrollo de T. viride en estos primeros días, aspecto que puede ser comprobado en estudios posteriores.
En el presente estudio, los análisis estadísticos mostraron que para el final de la prueba el crecimiento de T. viride fue significativamente menor que el de su testigo (p < 0,05) (véase, figura 1), lo que probablemente ratifica que existe interacción ente Purpureocillium sp. cepa UdeA0106 y T. viride. Sin embargo, hace falta demostrar qué tipo de interacciones se presentan en campo, con el fin de definir si el uso combinado de estos agentes representa o no alguna desventaja, al ser utilizados en forma simultanea dentro de programas de manejo integrado.
Con respecto a las evaluaciones de los productos fitosanitarios, las pruebas realizadas in vitro mostraron que el hongo Purpureocillium cepa UdeA0206 presentó mayor afección en el crecimiento vegetativo comparado con la germinación de conidios. Esto fue observado también por Bruck (2009) en un estudio de compatibilidad de productos fitosanitarios con M. anisopliae. En el caso particular del tratamiento con el insecticida Engeo® (Thiametoxan), en la presente investigación se observó que este producto no afecta el desarrollo de los tubos germinativos de Purpureocillium sp. cepa UdeA0106, lo cual también fue registrado por Neves et al. (2001) para el hongo B. bassiana. Contrario a lo esperado en este tratamiento, el hongo Purpureocillium sp. cepa UdeA0106 presentó un leve aumento en el porcentaje de germinación en comparación con el observado en su testigo, esto mismo fue descrito para B. bassiana, con el mismo agroquímico, por Cavalcanti et al. (2002).
Así mismo, los resultados obtenidos en la presente investigación mostraron que la cepa UdeA0106 tampoco presentó inhibición al enfrentarse con los fungicidas Tachigaren® (Hymexazol), Terrazole® (Etridiazole), Previcur® (propamocarb), Moncut® (Flutolanil) y Rhapsody® (Bacillus subtillis). En este enfrentamiento no se observó ningún efecto de inhibición en la germinación.
Con respecto al crecimiento vegetativo de Purpureocillium sp. cepa UdeA0106 en combinación con Thiametoxan, la tendencia mostró que el efecto inhibitorio solo se presentó en los primeros 5 días de la prueba, ya que para el final de la misma (día 10) su crecimiento fue similar al de su testigo. Con respecto a este fenómeno de recuperación para el día 10, se sugiere la hipótesis de que en los primeros 5 días en presencia del insecticida, el hongo pudiera presentar cierta adaptación relacionada con la degradación y metabolismo del compuesto, lo cual se evidenciaría en la capacidad de continuar con el crecimiento vegetativo hasta el final de la prueba. En este sentido, y al igual que en lo observado en los procesos de germinación, Andaló et al. (2004), Cavalcanti et al. (2002) y Moino y Alves [(1998), citados por Neves et al. (2001)], sugieren que un mecanismo fisiológico de resistencia a insecticidas en algunos hongos, está relacionado con la capacidad de metabolizar los componentes activos de los químicos, los cuales pueden convertirse en sustancias que serían aprovechadas como nutrientes secundarios. Por otra parte, estos investigadores también han expuesto que en un medio tóxico, el hongo podría estar haciendo un esfuerzo reproductivo para aumentar la producción de conidias como una estrategia de escape frente a la presencia del tóxico en el medio.
Aun cuando el efecto del insecticida sobre el crecimiento de la cepa UdeA0106 en los primeros tiempos de evaluación (día 5) fue altamente significativo (p < 0,001, 25% de inhibición), biológicamente no se considera una reducción alta del crecimiento, cuando se compara con los registros de Anees et al. (2010) y Batista (2001) para la influencia de insecticidas como Lorsban® (clorpirifos) y Deltamethrin, sobre el desarrollo de los hongos entomopatógenos M. anisopliae y B. bassiana, respectivamente. Estas sustancias fueron altamente tóxicas y ocasionaron inhibición completa de los hongos evaluados. Además, los datos mostrados en investigaciones con organismos del mismo grupo taxonómico que Purpureocillium sp. cepa UdeA0106, combinados con Thiametoxan, concuerdan con lo obtenido en este estudio. Batista et al. (2001) y Neves et al. (2001) indicaron la compatibilidad del insecticida Thiamethoxam con B. bassiana, M. anisopliae y P. lilacinus, al demostrar que no hubo efecto negativo en el crecimiento vegetativo y la germinación de las conidias cuando fueron tratadas con este insecticida. En este mismo sentido, la presencia del fungicida Previcur® (propamocarb) no causó efecto negativo en el desarrollo de Purpureocillium sp. cepa UdeA0106. Durante la prueba en la que se enfrentó el hongo con este agroquímico, el crecimiento y la germinación fueron similares a las de sus testigos, es decir, existe compatibilidad in vitro entre estos dos mecanismos de control. Una de las posibles explicaciones a lo observado, podría deberse a la diferencia de las características del grupo de organismos contra los que va dirigido el agroquímico; se ha propuesto que Purpureocillium sp. cepa UdeA0106 pertenece a los Clavicipales, mientras que los patógenos contra los que actúa el producto pertenecen al grupo de los Oomycotas (Bremia spp., Peronospora spp., Phytophtohora spp., Plasmopara spp., Pseudoperonospora spp., Pythium). De igual forma, Loureiro et al. (2002) demostraron que B. bassiana no se afectó en presencia de Metalaxil ya que pertenece a un grupo de organismos no sensibles a este compuesto. El fenómeno de compatibilidad entre este fungicida (propamocarb) y un hongo entomopatógeno, también fue observado por Durán (2004) para B. bassiana. Datos muy similares se comunicaron en un estudio realizado por Andaló et al. (2004) en el que hubo compatibilidad de B. bassiana con el fungicida Pencicurom.
El hecho de que algunos de los productos químicos evaluados en la presente investigación no ejercieran efecto inhibitorio sobre la cepa en estudio, representaría una ventaja en campo, en donde la aplicación conjunta de microorganismos y químicos podrían tener un efecto sinérgico contra la plaga (Purwar y Sachan 2005, Vásquez et al. 2004). Sin embargo, algunos productos químicos sí ejercieron inhibición completa del crecimiento vegetativo de Purpureocillium sp. cepa UdeA0106. Al ser combinada esta con los fungicidas Carbovax® (Carboxin + Thiram), Tachigaren® (Hymexazol) y Terrazole® (Etridiazole) en la dosis recomendada comercialmente, se observó que estas sustancias ejercen efecto negativo sobre el hongo, interfiriendo con su metabolismo y actuando, probablemente, de la misma manera como lo hacen con los hongos fitopatógenos para los que han sido fabricados (Loureiro et al. 2002).
El efecto adverso de Carboxin + Thiram también fue analizado por Pavone y Dorta (2010), quienes informaron de la inhibición completa sobre el crecimiento del hongo entomopatógeno Nomuraea rileyi por exposición a estas sustancias. Resultados similares han sido observados en otras investigaciones, en las que se mencionan algunos fungicidas comerciales con diferentes ingredientes activos de amplio espectro, ocasionando los mismos efectos de inhibición completa en el crecimiento vegetativo de B. bassiana y M. anisopliae (Karnataka 2007, Loureiro et al. 2002). Los datos obtenidos en este estudio demuestran que Carbovax® (Carboxin + Thiram) inhibió, además del crecimiento vegetativo de Purpureocillium sp. cepa UdeA0106, la germinación de conidios. Estos resultados apuntan que el uso combinado de Purpureocillium sp. cepa UdeA0106 y este fungicida, podría traer consigo incompatibilidades que generan pobre desempeño del hongo. Igual fenómeno ha sucedido con otros fungicidas en hongos como B. bassiana y M. anisopliae (Andaló 2004, Bruck 2009, Yáñez y France 2010). En contraste con los resultados obtenidos para Purpureocillium sp. cepa UdeA0106, Roberti et al. (2006) proporcionaron resultados distintos del efecto Carboxin y Thiram sobre algunas especies de Trichoderma. Estos investigadores observaron que este hongo no fue sensible a los compuestos químicos a los que se enfrentó in vitro, por el contrario, hubo sinergismo entre fungicida y biocontrolador haciendo más potente la combinación contra fitopatógenos. Para explicar este hecho, los autores argumentaron que Carboxin no daña el plasmalema, mientras que el Thiram no produce cambios en la permeabilidad de la membrana celular de este hongo (Kumar y Dubey 2001, citados por Roberti et al. 2006). Una posible explicación a lo sucedido con Purpureocillium sp. cepa UdeA0106 sometida a la acción de Carboxin y Thiram, podría estar relacionada con la inhibición de la síntesis de ARN y la respiración celular, efectos indicados en la ficha técnica del producto como mecanismo de acción sobre los hongos. Por otra parte, los efectos de inhibición en el crecimiento de Purpureocillium sp. cepa UdeA0106 por el fungicida Terrazole® (Etridiazole), encontrados en este estudio, son distintos a los resultados reportados por Bruck (2009) para M. anisopliae en presencia del mismo compuesto. Estos resultados y los ya mencionados para Trichoderma sp., se presentan como un soporte para inferir que la compatibilidad con agroquímicos de la misma naturaleza, puede ser totalmente contraria en organismos de distintos géneros. Debido a lo anterior, surge la necesidad de hacer estudios específicos para cada biocontrolador, así como la necesidad de verificar los resultados en campo para determinar el efecto de estos productos sobre Purpureocillium sp. cepa UdeA0106.
Con respecto al fungicida Moncut® (Flutolanil), este ejerció efecto moderado sobre el crecimiento vegetativo del hongo UdeA0106, pero no afectó su germinación. De acuerdo con Loureiro (2004), la inhibición del crecimiento micelial no es necesariamente un indicador de la esporulación y viabilidad de las conidias (y viceversa), tal y como fue observado en el presente estudio. Es importante anotar que, debido al uso extensivo de productos de síntesis química, estos fueron los que se evaluaron en mayor proporción en la presente investigación. Sin embargo, el producto comercial Rhapsody®, que contiene como ingrediente activo una cepa de Bacillus subtilis, fue incluido en los tratamientos debido a que es utilizado cada vez más en programas de manejo de fitopatógenos en campo. La bacteria B. subtilis ha sido registrada como controlador de algunos hongos fitopatógenos, gracias a la producción de sustancias antifúngicas (Bing et al. 2009, Leelasuphakul et al. 2008, Singh et al. 2008). Entre los compuestos liberados por B. subtillis, se mencionan enzimas como quitinasa, B-1,3, glucanasas y otras sustancias que degradan los principales componentes de la pared celular y algunos polímeros estructurales de las hifas de hongos (Feofilova 2010). Adicionalmente, esta tiene la capacidad de producir algunos compuestos antifúngicos volátiles que hacen que sea usado con frecuencia en distintos cultivos (Leelasuphakul et al. 2008). En el presente estudio se pudo observar que la combinación de Rhapsody® con Purpureocillium sp. cepa UdeA0106 produjo inhibición del crecimiento vegetativo en 84% desde los primeros días, alcanzado 87% de inhibición al final de la prueba (día 10). Los potentes mecanismos de B. subtillis contra los fitopatógenos anteriormente descritos, pudieron ser la causa probable del deterioro en el desarrollo miceliar del entomopatógeno UdeA0106, aspecto que debe ser tenido en cuenta al momento de realizar aplicaciones conjuntas de estos dos microorganismos.
Debido a que todas las evaluaciones del presente estudio fueron hechas en laboratorio, es necesario realizar estas mismas evaluaciones en campo, dado que en algunos casos se ha observado que algunos productos con alta toxicidad in vitro sobre entomopatógenos, al ser evaluados en campo, no muestran el mismo efecto. Esto debido a todas las condiciones ambientales que rodean la interacción producto químico-biocontrolador (Andaló 2004, Moino y Alves 1998, citado por Loureiro et al. 2002).
AGRADECIMIENTOS
Este trabajo contó con el apoyo del personal del Grupo BIOMA de la Universidad de Antioquia. Agradecimiento especial a la empresa Flores Esmeralda S. A C. I quienes suministraron el material necesario para las evaluaciones y demostraron siempre su interés en este estudio. Este proyecto fue financiado por el Ministerio de Agricultura y Desarrollo Rural, bajo el proyecto ''Búsqueda de una solución ecológica a Scutigerella sp. para su manejo en cultivos de flores''. Código200784771-156.
REFERENCIAS
Alizadeh A, Samih MA, Khezri M, Riseh RS. 2007. Compatibility of Beauveria bassiana (Bals.) Vuill. with several pesticides. International Journal of Agriculture and Biology, 9 (1): 31-34. [ Links ]
Ambethgar V. 2009. Potential of entomopathogenic fungi in insecticide resistance management (IRM): a review. Journal of Biopesticides, 2 (2): 177-193. [ Links ]
Anastasiadis IA, Giannakou IO, Prophetou-Athanasiadou DA, Gowen SR. 2008. The combined effect of the application of a biocontrol agent Paecilomyces lilacinus, with various practices for the control of root-knot nematode. Crop Protection, 27: 352-361. [ Links ]
Andaló V, Moino A, Santa L, Giselle C. 2004. Compatibilidade de Beauveria bassiana com agrotóxicos visando o controle da cochonilhada- raiz-do-cafeeiro Dysmicoccus texensis Tinsley (Hemiptera: Pseudococcidae). Neotropical Entomology, 33 (4): 463-467. [ Links ]
Anees M, Edel-Hermann V, Gordon HL, Heraud C, Steinberg C. 2010. Characterization of field isolates of Trichoderma antagonistic against Rhizoctonia solani. Fungal Biology, 114: 69-701. [ Links ]
Bailey KL, Boyetchko SM, Längle T. 2010. Social and economic shaping the future of biological control: A Canadian perspective on the factors affecting the development and use of microbial biopesticide. Biological Control, 52: 221-229. [ Links ]
Batista A, Almeida JE, Lamas C. 2001. Effect of Thiamethoxam on entomopathogenic microorganisms. Neotropical Entomology 30 (3): 437-447. [ Links ]
Bing L, Hongping Q, Heinrich LB, Qingmei Z, Yufei G. 2009. Biological control of take-all in wheat by endophytic Bacillus subtilis E1R-j and potential mode of action. Biological Control, 49: 277-285. [ Links ]
BLAST [Internet]. 2013. BLAST®. Basic Local Alignment Search Tool. Fecha de acceso: 10 de marzo de 2011. Disponible en: http://blast.ncbi.nlm.nih.gov/Blast.cgi. [ Links ]
Bruck DJ. 2009. Impact of fungicides on Metarhizium anisopliae in the rhizosphere, bulk soil and in vitro. BioControl, 54: 597-606. [ Links ]
Butt T, Copping L. 2000. Fungal biological control agents. Pesticide Outlook, 186-191. [ Links ]
Castiglioni E, Vendramin JD, Alves-Batista S. 2003. Compatibiidad de Beauveria bassiana y Metarhizium anisopliae con NimKol-L para el combate de Heterotermes tenuis. Manejo Integrado de Plagas y Agroecología, 69: 38-44. [ Links ]
Cavalcanti RS, Moino A, Souza GC, Arnosti A. 2002. Efeito dos produtos fitossanitários fenpropatrina, imidacloprid, iprodione e tiametoxam sobre o desenvolvimento do fungo Beauveria bassiana (Bals.) Vuill. Arquivos do Instituto Biológico, 69 (3): 17-22. [ Links ]
Charudattan R. 2001. Biological control of weed by means of plant pathogens: Significance for integrated weed management in modern agro-ecology. BioControl, 46: 229-260. [ Links ]
Corredor IC, Cepero MC, Restrepo S. 2007. Evaluación de la susceptibilidad de hongos endófitos aislados de rosa (rosa híbrida) a fungicidas comerciales. Revista Colombiana de Biotecnología, 9 (1): 59-74. [ Links ]
Cuthbertson AGS, Walters FA, Deppe C. 2005. Compatibility of the entomopathogenic fungus Lecanicillium muscarium and insecticides for eradication of sweetpotato whitefly, Bemisia tabaci. Mycopathologia, 160: 35-41. [ Links ]
Cuthbertson AGS, Blackburn LF, Northing P, Luo W, Cannon RJC, Walters KFA. 2008. Further compatibility tests of the entomopathogenic fungus Lecanicillium muscarium with conventional insecticide products for control of sweetpotato whitefly, Bemisia tabacion poinsettia plants. Insect Science, 15: 355-360. [ Links ]
Cuthbertson AGS, Blackburn LF, Northing P, Luo W, Cannon RJC, Walters KFA. 2010. Chemical compatibility testing of the entomopathogenic fungus Lecanicillium muscarium to control Bemisia tabaci inglasshouse environment. International Journal of Environmental Science and Technology, 7 (2): 405-409. [ Links ]
Denoth M, Frid L, Myers JH. 2002. Multiple agents in biological control: improving the odds? Biological Control, 24: 20-30. [ Links ]
Dubey SC, Suresh M, Singh B. 2007. Evaluation of Trichoderma species against Fusarium oxysporum f. sp. ciceris for integrated management of chickpea wilt. Biological Control, 40 (1): 118-127. [ Links ]
Durán MJ. 1998. Uso de Beauveria bassiana (Balsamo) Vuillemin (Deuteromycota: Hyphomycetes) como alternativa de control del picudo del chile Anthonomus eugenii Cano (Coleoptera: Curculionidae). [Tesis de maestría]. [Turrialba (Costa Rica)]: Centro Agronómico Tropical de Investigación y Enseñanza. p. 111. [ Links ]
Durán J, Carballo M, Hidalgo E. 2004. Efecto de fungicidas sobre la germinación y el crecimiento de Beauveria bassiana. Manejo Integrado de Plagas y Agroecología, 71: 73-78. [ Links ]
Ezziyyani M, Pérez C, Requena ME, Ahmed SA, Candela ME. 2004. Trichoderma harzianum como biofungicida para el biocontrol de Phytophthora capsici en plantas de pimiento (Capsicum annuum L.). Anales de Biología, 26: 35-45. [ Links ]
Feofilova EP. 2010. The fungal cell wall: modern concepts of its composition and biological function. Microbiology, 79 (6): 723-733. [ Links ]
Ganassi S, Grazioso P, Moretti A, Sabatini MA. 2010. Effects of the fungus Lecanicillium lecanii on survival and reproduction of the aphid Schizaphis graminum. BioControl, 55: 299-312. [ Links ]
Infante D, Martínez B, González N, Reyes Y. 2009. Mecanismos de acción de Trichoderma frente a hongos fitopátogenos. Protección Vegetal, 24 (1): 14-21. [ Links ]
Klingen I, Haukeland S. 2006. The soil as a reservoir for natural enemies of pest insects and mites with emphasis on fungi and nematodes. En: Eilenberg J, Hokkanen HMT, editores. An ecological and societal approach to biological control. Dordrecht: Springer. p. 145-211. [ Links ]
Karnataka J. 2007. Effect of agrochemicals on growth and sporulation of Metarhizium anisopliae (Metschnikoff) Sorokin. Journal of Agricultural Sciences, 20 (2): 410-413. [ Links ]
Kumar D, Dubey SC. 2001. Management of collar rot of pea bythe integration of biological and chemical methods. Indian Phytopathol, 54:62-66. [ Links ]
Leelasuphakul W, Hemmanee P, Chuenchitt S. 2008. Growth inhibitory properties of Bacillus subtilis strains and their metabolites against the green mold pathogen (Penicillium digitatum Sacc.) of citrus fruit. Postharvest Biology and Technology, 48: 113-121. [ Links ]
Loureiro E, Moino A, Arnosti A, De Souza G. 2002. Efeito de productos fitossanitarios químicos utilizados em alfase e crisantemo sobre fungus enomopatogenicos. Neotropical Entomology, 31 (2): 263-269. [ Links ]
Loureiro E, Moino A. 2006. Patogenicidade de fungos hifomicetos aos pulgões Aphis gossypii Glover e Myzus persicae (Sulzer) (Hemiptera: Aphididae). Neotropical Entomology, 35 (5): 660-665. [ Links ]
Luangsa JJ, Houbraken J, van Dorrn T, Hong SB, Borman AM, Hygel- Jones NL, Samson RA. 2011. Purpureocillium, a new genus for the medically important Paecilomyces lilacinus. FEMS Microbiology Letter, 321 (2): 141-149. [ Links ]
Luz C, Bastos MC, Nunes LF. 2007. In vitro susceptibility to fungicides by invertebrate pathogenic and saprobic fungi. Mycopathologia, 164: 39-47. [ Links ]
Meyer SL, Roberts DP. 2002. Combinations of biocontrol agents for management of plant-parasitic nematodes and soilborne plantpathogenic fungi. The Journal of Nematology, 34 (1): 1-8. [ Links ]
Mochi DA, Monteiro AC, Barbosa JC. 2005. Action of pesticides to Metarhizium anisopliae in soil. Neotropical Entomology, 34 (6): 961-971. [ Links ]
Moino A, Batista S. 1999. Efeito antagônico de Trichoderma sp. no desenvolvimento de beauveria bassiana (Bals.) Vuill. e Metarhizium anisopliae (Metsch.) Sorok. Scientia Agricola, 56 (1): 217-224. [ Links ]
Morales J. 2009. Determinación de la patogenicidad in vitro de estructuras tipo II y conidias de la cepa UdeA 0106 sobre Scutigerella sp. y aislamiento de hongos a partir de muestras de sinfílidos y suelos en la Ceja (Antioquia). [Tesis de pregrado]. [Medellín (Colombia)]: Universidad de Antioquia. p. [ Links ] 56.
Morales-Rodríguez A, Peck DC. 2009. Synergies between biological and neonicotinoid insecticides for the curative control of the white grubs Amphimallon majale and Popillia japonica. Biological Control, 51: 169-180. [ Links ]
Mourão SA, Vilela EF, Zanuncio JC, Zambolim L, Tuelher ES. 2003. Selectivity of insecticides and fungicides to the entomopathogenic fungus Beauveria bassiana. Neotropical Entomology, 32 (1): 103-106. [ Links ]
Muhammad RA, Muhammad HB, Muhammad A, Muhammad A, Shahbaz TS. 2010. Compatibility of entomopathogenic fungi, Metarhizium anisopliae and Paecilomyces fumosoroseus with selective insecticides. Pakistan Journal of Botany, 42 (6): 4207-4214. [ Links ]
Navarro R, Gaviria B 2001. Resistencia de variedades de crisantemo a la pudrición de raíces (C. destructan, Zinssin) Schalten. Reinfestación por nematodos en suelos y nematofauna asociada a las aguas del riego. Revista Universidad Católica de Oriente, 3: 30-34. [ Links ]
Neves P, Hirose E, Tchujo P, Moino A. 2001. Compatibility of entomopathogenic fungi with neonicotinoid insecticides. Neotropical Entomology, 30 (2): 263-268. [ Links ]
Olán JF, Cortez H. 2003. Efecto de tres fungicidas sobre siete aislamientos del entomopatógeno Lecanicillium (= Verticillium) lecanii. Manejo Integrado de Plagas y Agroecología, 69: 21-26. [ Links ]
Pavone D, Dorta B. 2010. Efecto de agroquímicos sobre el desarrollo del hongo entomopatógeno Nomuraea rileyi y su virulencia sobre Spodoptera frugiperda. Bioagro, 22 (2): 105 -114. [ Links ]
Pearson DE, Callaway RM. 2005. Indirect nontarget effects of hostspecific biological control agents: Implications for biological control. Biological Control, 35: 288-298. [ Links ]
Purwar JP, Sachan GC. 2005. Synergistic effect of entomogenous fungi on some insecticides against Bihar hairy caterpillar Spilarctia obliqua (Lepidoptera: Arctiidae). Microbiological Research, 161 (1): 38-42. [ Links ]
Quesada-Moraga E, Ruiz-García A, Santiago-Álvarez C. 2006. Laboratory evaluation of entomopathogenic fungi Beauveria bassiana and Metarhizium anisopliae against puparia and adults of Ceratitis capitata (Diptera: Tephritidae). Journal of Economic Entomology, 99 (6): 1955-1966. [ Links ]
Ramaraje NV, Govindu HC, Shivashankara KS. 1967. The effect of certain insecticides on the entomogenous fungi Beauveria bassiana and Metarhizium anisopliae. Journal of Invertebrate Pathology, 9 (3): 398-403. [ Links ]
Reino JL, Guerrero RF, Hernández R, Collado I. 2008. Secundary metabolites from species of de biocontrol agent Tichoderma. Phytochemistry Reviews, 7 (1): 89-123. [ Links ]
Roberti R, Badiali F, Pisi A, Veronesi A, Pancaldi D, Cesari A. 2006. Sensitivity of Clonostachys rosea and Trichoderma spp. as potential biocontrol agents to pesticides. Journal Phytopathology, 154: 100-109. [ Links ]
Roberts D, Lohrke S, Meyer S, Buyer J, Bowers J, Baker C, Li W, Lewis J, Chung S. 2005. Biocontrol agents applied individually and in combination for suppression of soilborne diseases of cucumber. Crop Protection, 24 (2): 141-155. [ Links ]
Roselló JL. 2003. Capacidad antagonista de Penicillium oxalicum Currie y Thom y Trichoderma harzianum Rifai frente a diferentes agentes fitopatógenos. [Tesis doctoral]. [Valencia (España)]. Universidad Politécnica de Valencia. p. 237. [ Links ]
Singh N, Pandey P, Dubey RC, Maheshwari DK. 2008. Biological control of root rot fungus Macrophomina phaseolina and growth enhancement of Pinus roxburghii (Sarg.) by rhizosphere competent Bacillus subtilis BN1. World Journal of Microbiology and Biotechnology, 24 (9): 1669-1679. [ Links ]
Spadaro D, Gullino ML. 2005. Improving the efficacy of biocontrol agents against soil borne pathogens. Crop Protection 24: 601-613. [ Links ]
Suárez-Meza LC, Fernández-Barbosa RJ, Valero NO, Gámez-Carrillo RM, Páez-Redondo AR. 2008. Antagonismo in vitro de Trichoderma harzianum Rifai sobre Fusarium solani (Mart.) Sacc, asociado a la marchitez en maracuyá. Revista Colombiana de Biotecnología, 10 (2): 35-43. [ Links ]
Thrane C, Funck JD, Tronsmo A. 2000. Substrate colonization, strain competition, enzyme production in vitro, and biocontrol of Pythium ultimum by Trichoderma spp. isolates P1 and T3. European Journal of Plant Pathology, 106: 215-225. [ Links ]
Vásquez CA, Saldarriaga Y, Pineda F. 2004. Compatibilidad del hongo entomopatógeno Beauveria bassiana con triflumuron. Revista Colombiana de Entomología, 30 (1): 13-16. [ Links ]
Vega FE, Goettel MS, Blackwell M, Chandler D, Jackson MA, Keller S, Koike M, Maniania NK, Monzon A, Ownley BH, Pell JK, Rangel D, Roy HE. 2009. Fungal entomopathogens: new insights on their ecology. Fungal Ecology, 2: 149-159. [ Links ]
Whipps JM. 2001. Microbial interactions and biocontrol in the rhizosphere. Journal of Experimental Botany, 52: 487-511. [ Links ]
Woo SL, Lorito M. 2007. Exploiting the interaction between fungal antagonists, pathogens and the plant for biocontrol. En: Vurro M, Gressel J, editores. Novel biotechnologies for biocontrol agent enhancement and management. Dordrecht: Springer. p. 107-130. [ Links ]
Yáñez M., France A. 2010. Effects of fungicides on the development of the entomopathogenic fungus Metarhizium anisopliae var. anisopliae. Chilean Journal of Agricultural Research, 70 (3): 390-398. [ Links ]
Zuluaga GF, Navarro AR, Gaviria GB. 2007. Uso de productos biorracionales para el manejo de sinfílidos (Scutigerella inmaculata N.) en cultivos ornamentales. Revista Universidad Católica de Oriente, 23: 31-40. [ Links ]